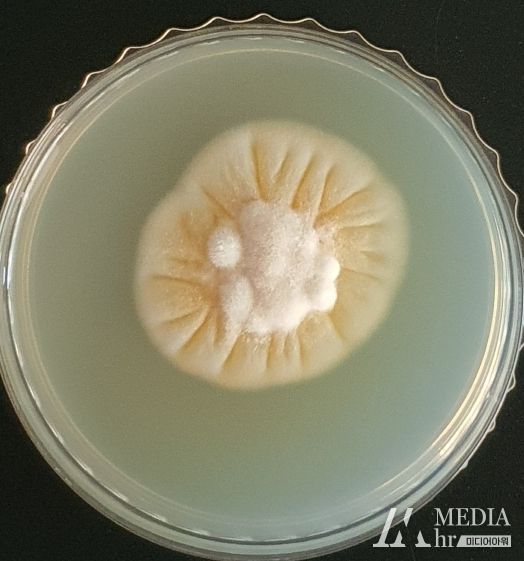

미디어아워 기자 | 산림청 국립산림과학원(원장 배재수)은 송이 인공 재배 기술 개발에 핵심 역할을 할 송이의 유전체(게놈) 정보를 완전히 해독하는 데 성공했다고 밝혔다.
송이는 살아있는 소나무의 뿌리에서만 필요한 영양분을 공급받아 살아가는 버섯으로 인공 재배가 까다롭다. 살아있는 소나무와 주변 환경이 어떻게 송이 생산을 가능케 하는지 정확히 파악하기 어려웠기 때문이다.
이러한 점을 해결하기 위해 국립산림과학원에서는 소나무에 접종되는 능력과 생장량이 우수한 것으로 선발된 송이(NIFoS 2001)의 유전체 정보를 해독했다.
해독된 송이의 유전체 크기는 162.6Mb이며, 15,947개의 유전자로 구성된 것으로 밝혀졌다. 해당 결과는 미국 미생물학회지'Microbiology Resource Announcements' 5월호에 게재됐다.
이번 연구 결과는 소나무의 나이, 영양상태, 토양 및 기후조건 등에 따른 송이의 반응을 유전체 수준에서 알아볼 수 있고, 현재 산림청에서 지원하는 송이산 가꾸기 사업과 인공 재배 실현에 필요한 다양한 정보를 제공할 수 있을 것으로 보인다.
국립산림과학원 산림미생물연구과 강민정 박사는 “송이 유전체 정보를 활용하면 버섯이 발생하기 전에 송이가 감염된 소나무를 판별할 수 있으며, 인공적인 송이 접종을 통한 인공 재배 기술개발도 가능할 수 있을 것”이라고 전했다.

